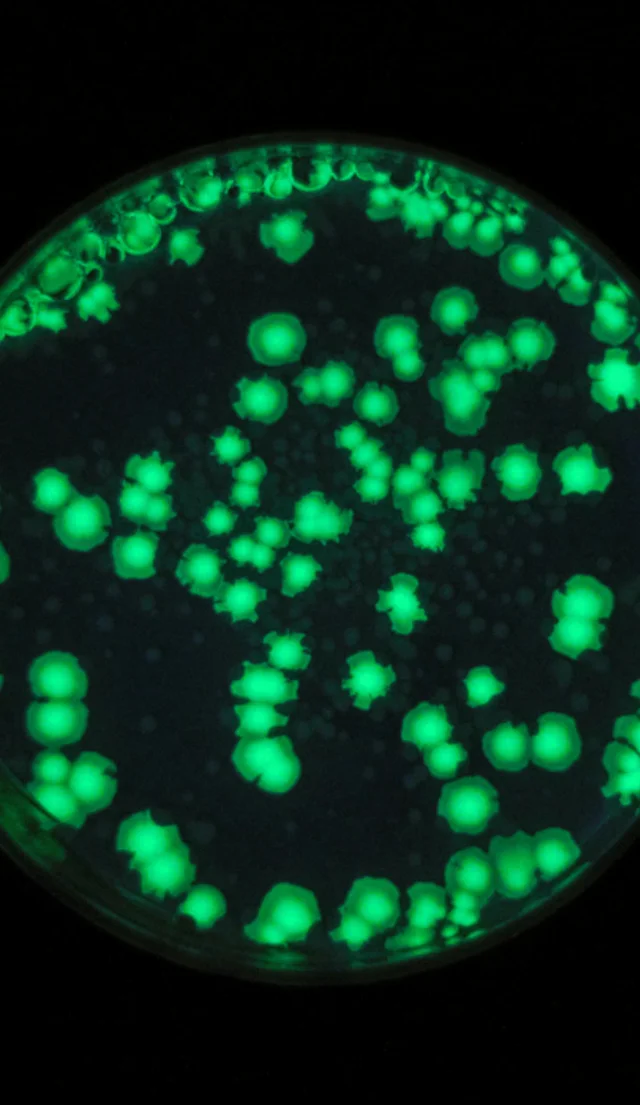

Neurophase
Neurophase explores the formation of biomolecular condensates by liquid-liquid phase separation (LLPS), and how this emerging field can lead to novel concepts to treat brain disorders and diseases.
Project summary
Purpose
Purpose Development of novel therapeutics to treat brain disorders and diseases.
Host university
University of Copenhagen (KU)
Funding per year
DKK 6,5M
Duration
Three years
Expected outcome
Viable startup that can raise seed or Series A financing

Project leaders
See who heads the Neurophase project on its mission to develop novel therapeutics to treat brain disorders and diseases.
“The depth of commitment and ambitions is palpable when you enter BII’s premises. Creating benefits for people and society is at the heart of everything”
Nikolaj Petersen
Former Entrepreneur in Residence